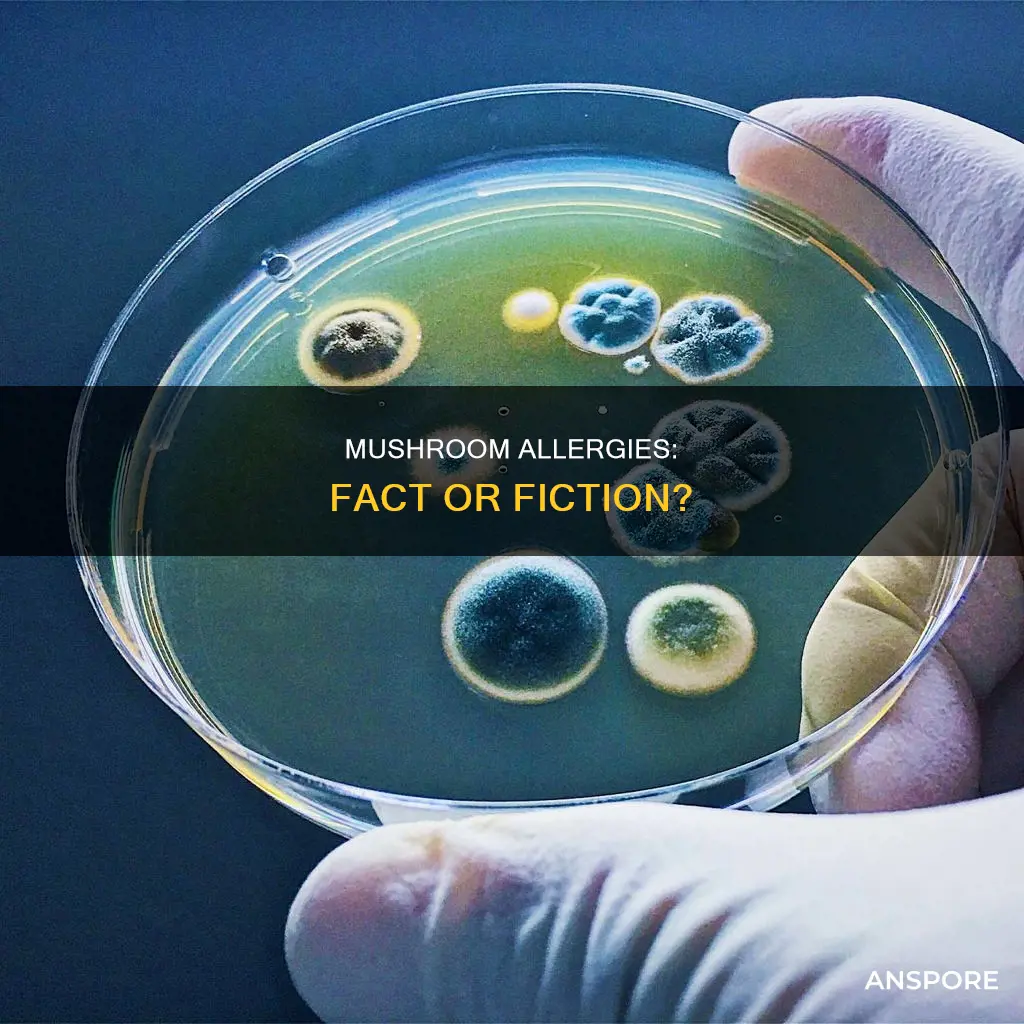
do mushroom allergies exist

Mushroom allergies do exist and can be triggered by the immune system's overreaction to proteins or moulds present in mushrooms. The primary cause of mushroom allergies is exposure to mushroom spores, which can occur through consumption, inhalation, or skin contact. Mushroom allergies are not very common, but they can be life-threatening. The symptoms can range from mild to severe, including hives, skin rashes, itching, swelling of the lips, tongue, throat, or face, difficulty breathing, asthma attacks, and stomach pain. Treatment options include over-the-counter antihistamines, prescribed corticosteroids, and, in emergency cases, epinephrine injections.
| Characteristics | Values |
|---|---|
| Allergy Type | Food Allergy, Fungus Food Allergy Syndrome (FFAS), Respiratory Allergy |
| Allergens | Mannitol, Mushroom Spores, Mushroom Proteins |
| Symptoms | Oral Allergy Syndrome, Anaphylaxis, Hives, Swelling of Lips/Tongue/Throat/Face, Difficulty Breathing, Stomach Pain, Sneezing, Runny Nose, Itchy Eyes, Asthma Attacks |
| Treatment | Avoid Mushrooms, Antihistamines, Corticosteroids, Epinephrine, Allergy Shots, Sublingual Immunotherapy |
| Prevalence | Unknown, Estimated Between 1-10% or 10-30% |
| Risk Factors | Exposure to Mushroom Spores, Cross-Reactivity with Airborne Fungi, Skin Contact, Ingestion, Inhalation |
Explore related products
What You'll Learn

Mushroom allergy symptoms
More severe symptoms can indicate anaphylaxis, a life-threatening allergic response that requires immediate medical attention. These symptoms include difficulty breathing, wheezing, dizziness, rapid or weak heartbeat, severe abdominal pain, swelling of the lips, face, or throat, gastrointestinal distress such as nausea, vomiting, or diarrhea, and a sudden drop in blood pressure. Inhalant allergies to mushroom spores can also cause respiratory symptoms in sensitive individuals, such as sneezing, coughing, wheezing, and shortness of breath. These symptoms can be particularly problematic for those with pre-existing respiratory conditions like asthma.
The most effective treatment for mushroom allergy is avoidance. Antihistamines can help alleviate mild symptoms, but they are ineffective in treating anaphylaxis. In such cases, epinephrine (adrenaline) is administered to rapidly reverse the symptoms. Allergy shots and sublingual immunotherapy are also treatment options, helping the immune system become less sensitive to the allergen over time.
It is important to note that the overall extent of mushroom allergies is not well understood, and the choice and recognition of species can be difficult. If an individual suspects they have a mushroom allergy, they should consult an allergist for diagnosis and treatment. Regular check-ups are also recommended to stay informed about any new developments in allergy treatment.
Oregon's New Approach to Decriminalizing Magic Mushrooms
You may want to see also

Mushroom allergy treatment
Mushroom allergies are not very common, but they can be a serious health concern for those affected. The overall extent of mushroom allergies is unknown, but it is estimated that they could affect 1% of people who eat mushrooms, or as many as 10-30% of people with other allergies.
The treatment for a mushroom allergy depends on the severity of the allergy and the patient's overall health. Mild allergic reactions can be treated with over-the-counter antihistamines, vitamin C, aloe vera, and epinephrine. Antihistamines can help to alleviate symptoms such as itching, hives, and rashes. Vitamin C is a natural antihistamine that can help reduce inflammation, and can be taken as a supplement or by eating vitamin C-rich foods such as citrus fruits, kiwi, strawberries, and broccoli. Aloe vera has anti-inflammatory properties and can soothe skin irritation caused by a mild allergic reaction.
For more severe symptoms, doctors may prescribe corticosteroids to reduce inflammation. In emergency cases, such as anaphylaxis, epinephrine (also known as adrenaline) may be administered. This medication can help reverse the symptoms of anaphylaxis and save the patient's life.
Allergy shots are another treatment option, which involve injecting small doses of the allergen into the body to help build up immunity. This treatment method is typically recommended for patients with severe allergies or those who don't respond well to medications. A relatively new treatment method called sublingual immunotherapy involves placing a tablet containing the allergen under the tongue.
The most effective way to prevent a mushroom allergy is to avoid exposure to mushrooms, including eating them and avoiding areas where they are grown or processed. Reading food labels carefully is crucial, as many processed foods may contain mushroom extracts.
Mushrooms: Water Solubility and its Benefits
You may want to see also

Mushroom allergy diagnosis
Another type of skin test used for mushroom allergy diagnosis is the intradermal test, where a diluted allergen is injected into the skin. If the injection site develops a small, solid bump, it indicates a positive reaction to the allergen. This test is typically used when the skin prick test is inconclusive or when the allergen is not suitable for the skin prick test.
Blood tests, on the other hand, measure the amount of Immunoglobulin E (IgE) antibodies in the blood. High levels of IgE antibodies suggest an allergy to mushrooms. Blood tests may take a few days for results, but they are useful for diagnosing allergies when skin tests are not feasible or when more detailed information is needed.
It is important to note that the overall extent of mushroom allergy is not precisely known. The allergic reaction can be caused by eating mushrooms or inhaling their spores, and different species of mushrooms can trigger various symptoms. The primary cause of mushroom allergy is the body's immune response to mushroom proteins, which can lead to the release of histamine and subsequent allergy symptoms.
Some common symptoms of mushroom allergy include skin irritation, hives, rashes, swelling of the lips, mouth, and throat, coughing, wheezing, vomiting, and diarrhoea. In severe cases, anaphylaxis can occur, which requires immediate medical attention and treatment with epinephrine.
Mushrooms: Heart Health Benefits and Risks
You may want to see also
Explore related products

Mushroom allergy prevalence
The prevalence of mushroom allergies is not well understood. While some sources estimate that mushroom allergies are rare, with only 1% of people experiencing allergic reactions from eating mushrooms, others suggest that mushroom allergies could be as common as pollen and mould allergies, affecting 10-30% of an allergic population.
Mushroom allergies can be caused by either consuming mushrooms or inhaling their spores. The allergic reaction is a result of the body interpreting mushroom proteins as foreign invaders. This triggers the immune system to release IgE antibodies and histamine, leading to various allergy symptoms.
The specific species of mushroom can also influence the prevalence of allergies. For example, the genus Chlorophyllum is unique to North America, while its close relatives, the genus Macrolepiota, are found in Europe. However, the majority of common mushroom families have not been extensively studied for their allergenic potential.
The diagnosis of mushroom allergies can be challenging due to the natural growth patterns of mushrooms, which can lead to allergenic contamination from other sources. Additionally, species selection and recognition can be difficult, further complicating research in this area. Skin prick tests and blood tests are available to confirm a mushroom allergy, but these tests may not always be conclusive.
While the exact prevalence of mushroom allergies remains uncertain, it is clear that allergic reactions to mushrooms can range from mild to severe. Mild reactions may include skin irritation, hives, rashes, and swelling of the lips, mouth, or throat. More severe reactions, known as anaphylaxis, can be life-threatening and require immediate medical attention.
Mushrooms: Mammals or Not?
You may want to see also

Mushroom allergy research
One challenge in mushroom allergy research is the vast number of mushroom species, with many of the larger and more common families remaining unexplored. The choice and recognition of species are difficult tasks, and naturally growing mushrooms are typically relied upon for research, increasing the risk of allergenic contamination. Some of the more well-known mushroom families, such as Cortinariaceae, Russulaceae, Lactariaceae, and Boletaceae, have not been extensively studied despite their significant spore production.
The primary cause of mushroom allergies is exposure to mushroom spores, which can occur through consumption, inhalation, or skin contact. Mushroom spores are a known cause of respiratory allergies, with aerosolised spores acting as inhalant allergens similar to pollen and mould spores. The role of mushroom spores as inhalant allergens has been established, with positive results in skin prick tests (SPTs) and bronchial provocation tests (BPTs).
Mushroom allergy symptoms can vary in severity, ranging from mild reactions such as hives, itching, and sneezing to severe and life-threatening anaphylaxis. The most effective treatment for mushroom allergies is avoidance, as antihistamines are ineffective in cases of anaphylaxis. Allergic reactions to mushrooms are immune system responses to the proteins or moulds present, with cross-reactivity between mould aeroallergens and mushroom proteins also observed.
Further research is needed to comprehensively understand mushroom allergies, identify causative allergens, and improve allergy management. The field of allergic cross-reactivity between fungal allergens and related foods, such as mycoprotein, requires more attention in both basic research and clinical practice.
Mushroom Supplements: Constipation Side Effect?
You may want to see also
Frequently asked questions
Yes, mushroom allergies do exist and can be triggered by the immune system's overreaction to proteins or moulds present in mushrooms. The symptoms can range from mild to severe and can be life-threatening in some cases.
The symptoms of a mushroom allergy can include hives, skin rash, itching, swelling of the lips, tongue, throat, or face, difficulty breathing, stomach pain, sneezing, coughing, wheezing, and shortness of breath. In rare cases, a mushroom allergy can lead to anaphylaxis, a severe and potentially life-threatening allergic reaction.
The most effective treatment for a mushroom allergy is to avoid consuming or coming into contact with mushrooms and their spores. This includes carefully reading food labels, asking about ingredients when dining out, and avoiding environments where mushrooms may be present, such as forests or damp, mouldy areas. Medications are often the first line of treatment, with antihistamines being used to alleviate mild symptoms and corticosteroids prescribed for more severe symptoms. In emergency cases, such as anaphylaxis, epinephrine (adrenaline) is administered.











































